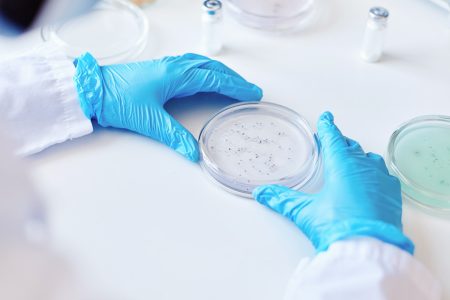
Θα φανταζόσουν ότι ένα μικρόβιο θα σου χαρίσει μακροζωία;

Ποδόσφαιρο
ΕΛΛΑΔΑ
ΔΙΕΘΝΗ
ΟΜΑΔΕΣ ΕΛΛΑΔΑ
ΚΟΡΥΦΑΙΕΣ ΟΜΑΔΕΣ
Μπάσκετ
ΕΛΛΑΔΑ
ΔΙΕΘΝΗ
ΟΜΑΔΕΣ ΕΛΛΑΔΑ
ΟΜΑΔΕΣ EUROLEAGUE
ΟΜΑΔΕΣ NBA
ΣΠΟΡ
ΑΘΛΗΜΑΤΑ
ΔΙΟΡΓΑΝΩΣΕΙΣ
BET
ΠΡΟΤΑΣΕΙΣ
TIPSTERS
ΣΤΟΙΧΗΜΑΤΙΚΕΣ
CASINO